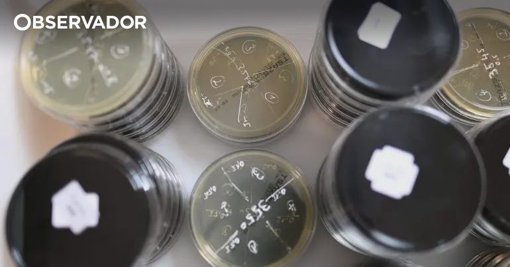

Deteção de Legionella em Oliveira do Bairro Leva a Medidas de Contenção em Pavilhão Municipal

A Câmara Municipal de Oliveira do Bairro confirmou a deteção da bactéria *legionella* em três dos oito balneários do Pavilhão Desportivo Municipal.
A descoberta ocorreu durante análises de rotina para o controlo da qualidade da água, levando à ativação imediata dos procedimentos técnicos e sanitários previstos. Em articulação com a delegada de Saúde da Unidade Local de Saúde da Região de Aveiro, foi decidido suspender a utilização dos duches nos balneários afetados como medida de precaução. No entanto, as restantes áreas dos balneários permanecem em utilização.
Os utentes estão a ser reencaminhados para outras instalações do Parque Desportivo Municipal, localizadas nas proximidades, para poderem tomar banho.
A decisão de manter o pavilhão em funcionamento, à exceção dos duches, foi tomada em conjunto pela autarquia e pela autoridade de saúde pública. O objetivo é garantir a continuidade das aulas de Educação Física do Agrupamento de Escolas e do Instituto Profissional da Bairrada, bem como os treinos e competições dos clubes desportivos, dada a falta de alternativas. O município do distrito de Aveiro assegurou que está a implementar as medidas corretivas necessárias, em conformidade com as orientações das autoridades de saúde, e a realizar um acompanhamento rigoroso do processo para garantir a segurança de todos os equipamentos.
A bactéria *legionella*, presente em meios aquáticos, pode causar uma infeção pulmonar grave conhecida como Doença dos Legionários.
Artigos
8




